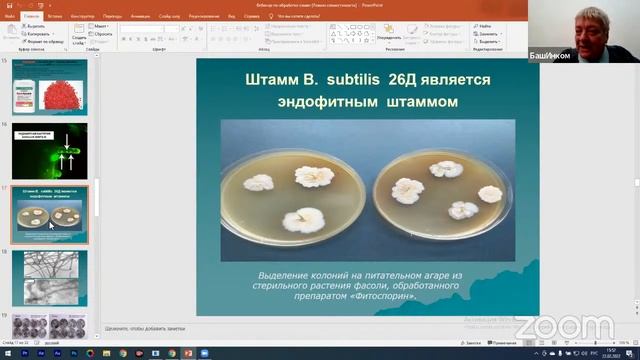
Обучение 1000 агрономов смотреть онлайн

Автор: Вкусные блюда от Марины Страница 2

Строим вольер для 44 собак. День 2 и 3.

Ворота на Газель в Новосибирске

Работа с фотографией. Как защитить себя и своих близких по фотографии.

ГАЗель НЕКСТ 6.3 для грузоперевозок. Эталонный экземпляр грузового тюнинга

Мой гараж.Отопление гаража буржуйкой. Печь в гараже.

Натяжные ролики для сцепления минитрактора! Закупаю мелочевку.

БЕТОН работает на СЖАТИЕ, а АРМАТУРА на РАСТЯЖЕНИЕ!!! (Так ли это?)

Где зарыты Ваши сокровища? НейроГрафика это. НейроДрево талантов и способностей.

Суп куриная лапша

Прикол. Сосиска сама крутится на сковородке)

Суп (бульон) с фрикадельками!?

ОБЗОР ПОКУПОК В "MAXIMA"

Мыловарение /мыло мороженое (кейпопсы)

РАССЫПЧАТЫЙ И НЕОПИСУЕМО ВКУСНЫЙ РИС С ЛЕГКИМ СЛИВОЧНЫМ ВКУСОМ.

Забавные факты и глупые вопросы (говорим по-английски)

перья зеленого лука

Новая рубрика готовим в месте я приготовил завтрак обед и ужин

Как я пересаживаю растения, секрет холодного кофе и мой макияж

Самый вкусный и быстрый способ приготовить мохито.?
Обучение 1000 агрономов

Омлет в мультиварке

Ярмарка в Москве. Подготовка, впечатления, покупки

Люблю приготовить что-нибудь вкусненькое

Когда решил "все сделать сам"
За каждым успешным каналом стоит личность, идея и сотни часов кропотливого труда. Если вы здесь, значит, автор «Вкусные блюда от Марины» уже сумел зацепить ваше внимание своим уникальным стилем или подачей. А мы на RUVIDEO позаботились о том, чтобы вы могли изучить весь архив его работ в максимально комфортных условиях — без лишней суеты и преград.
Почему за работами канала «Вкусные блюда от Марины» так интересно наблюдать? Всё просто: это честный контент, который находит отклик в сердцах зрителей. На нашем ресурсе вы можете смотреть онлайн все видео любимого автора бесплатно и в хорошем качестве. Нам важно, чтобы вы видели каждую деталь и слышали каждый нюанс, поэтому мы используем только стабильные плееры из открытых источников Rutube.
Следите за новинками канала, пересматривайте старые шедевры и открывайте для себя новые грани творчества «Вкусные блюда от Марины». Мы постоянно обновляем ленту, чтобы у вас под рукой всегда были самые свежие выпуски. Никаких сложных регистраций — только вы и творчество, которое вдохновляет. Приятного вам путешествия по миру авторского контента на RUVIDEO!
Видео взято из открытых источников Rutube. Если вы правообладатель, обратитесь к первоисточнику.